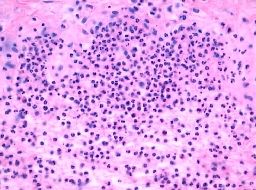

北京京城皮肤医院提供网络预约挂号服务
预约挂号热线:010-64888999
三级专科
医保定点
舒适环境
无假日
什么是念球菌性皮炎?北京京城皮肤医院指出,念球菌性皮炎是常见的皮肤病类型中的一种,常常由于各种原因等而引起皮肤症状,而且发展迅速。北京京城皮肤医院就给大家讲解什么是念球菌性皮炎。帮助大家及早的发现和预防皮肤疾病的发生。
什么是念球菌性皮炎?北京京城皮肤医院指出,念球菌性皮炎多发于皮肤皱褶部如腹股沟,肛周臀裂部,腋窝,女性乳房下皮肤,也可发于龟头包皮内和大小阴唇,指甲沟和口角等处。 皮疹多呈局部皮肤潮红,轻度肿胀,表面可糜烂,分泌物有异臭味。有时也可呈干燥,脱屑。
如果您想要了解更多什么是念球菌性皮炎相关信息,可以选择挂号,您将得到满意的答复。
推荐阅读:过敏性皮炎的诱因
推荐阅读:夏季易发的皮炎
推荐阅读:夏季皮炎图片夏季皮炎什么样